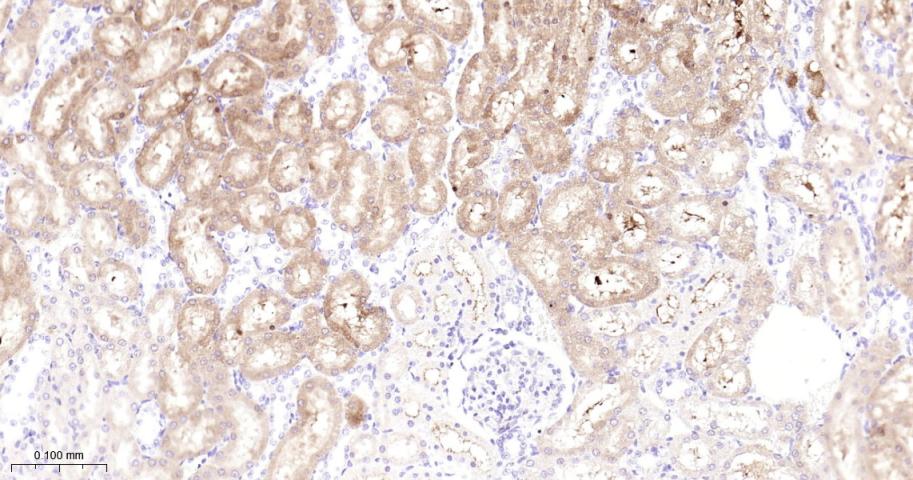
GBA Recombinant Rabbit mAb(bsm

| 产品编号 | bsm-52907R |
| 英文名称 | GBA Recombinant Rabbit mAb |
| 中文名称 | β-葡萄糖脑苷脂酶重组兔单抗 |
| 英文别名 | Glucosidase beta; Acid beta glucosidase; Acid beta-glucosidase; Alglucerase; beta glucocerebrosidase; BETA GLUCOSIDASE, ACID; beta-glucocerebrosidase; betaGC; D glucosyl N acylsphingosine glucohydrolase; D-glucosyl-N-acylsphingosine glucohydrolase; EC 3.2.1.45; Gba protein; GBA1; GC antibody GCase; GCB; GLCM_HUMAN; GLUC; Glucocerebrosidase(alt.); Glucocerebrosidase; GLUCOCEREBROSIDASE PSEUDOGENE; Glucosidase beta; Glucosidase, beta, acid; Glucosidase, beta; acid(includes glucosylceramidase); Glucosylceramidase; Imiglucerase; Lysosomal glucocerebrosidase. |
| 产品应用 | WB=1:500-2000, IHC-P=1:100-500, IHC-F=1:100-500, IF=1:100-500
Not yet tested in other applications.
Optimal working dilutions must be determined by the end user. |
| 交叉反应 | Human, Mouse, Rat |
| 抗体来源 | Rabbit |
| 免疫原 | A synthesized peptide derived from human Lysosomal acid GCase |
| 亚型 | IgG |
| 性状 | Liquid |
| 纯化方法 | affinity purified by Protein A |
| 克隆类型 | Recombinant |
| 理论分子量 | 56 kDa |
| 浓度 | 1mg/ml |
| 储存液 | 0.01M TBS (pH7.4) with 1% BSA, 0.02% Proclin300 and 50% Glycerol. |
| 研究领域 | Cancer > Cancer Metabolism > Metabolic signaling pathway > Metabolism of lipids and lipoproteins Metabolism > Pathways and Processes > Metabolic signaling pathways > Energy transfer pathways > Energy Metabolism Metabolism > Pathways and Processes > Metabolic signaling pathways > Lipid and lipoprotein metabolism > Lipid metabolism Metabolism > Types of disease > Cancer Metabolism > Types of disease > Neurodegenerative disease Neuroscience > Neurology process > Neurodegenerative disease > Parkinson's disease Signal Transduction > Metabolism > Energy Metabolism Signal Transduction > Metabolism > Lipid metabolism |
| 亚基 | Interacts with saposin-C. Interacts with SCARB2. |
| 亚细胞定位 | Lysosome membrane. Interaction with saposin-C promotes membrane association. |
| 相似性 | Belongs to the glycosyl hydrolase 30 family. |
| 保存条件 | Shipped at 4℃. Store at -20℃ for one year. Avoid repeated freeze/thaw cycles. |
| 注意事项 | This product as supplied is intended for research use only, not for use in human, therapeutic or diagnostic applications. |
| 背景资料 | This gene encodes a lysosomal membrane protein that cleaves the beta-glucosidic linkage of glycosylceramide, an intermediate in glycolipid metabolism. Mutations in this gene cause Gaucher disease, a lysosomal storage disease characterized by an accumulation of glucocerebrosides. A related pseudogene is approximately 12 kb downstream of this gene on chromosome 1. Alternative splicing results in multiple transcript variants. [provided by RefSeq, Jan 2010] |
| 应用 | 推荐稀释比例 |
| {WB} | {1:500-2000} |
| {IHC-P} | {1:100-500} |
| {IHC-F} | {1:100-500} |
| {IF} | {1:100-500} |
Paraformaldehyde-fixed, paraffin embedded Mouse Placenta; Antigen retrieval by boiling in sodium citrate buffer (pH6.0) for 15 min; Antibody incubation with GBA Monoclonal Antibody, Unconjugated(bsm-52907R) at 1:200 overnight at 4°C, followed by conjugation to the bs-0295G-HRP and DAB (C-0010) staining.
Paraformaldehyde-fixed, paraffin embedded Rat Placenta; Antigen retrieval by boiling in sodium citrate buffer (pH6.0) for 15 min; Antibody incubation with GBA Monoclonal Antibody, Unconjugated(bsm-52907R) at 1:200 overnight at 4°C, followed by conjugation to the bs-0295G-HRP and DAB (C-0010) staining.
Paraformaldehyde-fixed, paraffin embedded Human Placenta; Antigen retrieval by boiling in sodium citrate buffer (pH6.0) for 15 min; Antibody incubation with GBA Monoclonal Antibody, Unconjugated(bsm-52907R) at 1:200 overnight at 4°C, followed by conjugation to the bs-0295G-HRP and DAB (C-0010) staining.
Paraformaldehyde-fixed, paraffin embedded Rat Colon; Antigen retrieval by boiling in sodium citrate buffer (pH6.0) for 15 min; Antibody incubation with GBA Monoclonal Antibody, Unconjugated(bsm-52907R) at 1:200 overnight at 4°C, followed by conjugation to the bs-0295G-HRP and DAB (C-0010) staining.
Paraformaldehyde-fixed, paraffin embedded Human Colon; Antigen retrieval by boiling in sodium citrate buffer (pH6.0) for 15 min; Antibody incubation with GBA Monoclonal Antibody, Unconjugated(bsm-52907R) at 1:200 overnight at 4°C, followed by conjugation to the bs-0295G-HRP and DAB (C-0010) staining.
Paraformaldehyde-fixed, paraffin embedded Rat Cerebrum; Antigen retrieval by boiling in sodium citrate buffer (pH6.0) for 15 min; Antibody incubation with GBA Monoclonal Antibody, Unconjugated(bsm-52907R) at 1:200 overnight at 4°C, followed by conjugation to the bs-0295G-HRP and DAB (C-0010) staining.
Paraformaldehyde-fixed, paraffin embedded Human Cerebrum; Antigen retrieval by boiling in sodium citrate buffer (pH6.0) for 15 min; Antibody incubation with GBA Monoclonal Antibody, Unconjugated(bsm-52907R) at 1:200 overnight at 4°C, followed by conjugation to the bs-0295G-HRP and DAB (C-0010) staining.
Paraformaldehyde-fixed, paraffin embedded Rat Kidney; Antigen retrieval by boiling in sodium citrate buffer (pH6.0) for 15 min; Antibody incubation with GBA Monoclonal Antibody, Unconjugated(bsm-52907R) at 1:200 overnight at 4°C, followed by conjugation to the bs-0295G-HRP and DAB (C-0010) staining.
Paraformaldehyde-fixed, paraffin embedded Human Kidney; Antigen retrieval by boiling in sodium citrate buffer (pH6.0) for 15 min; Antibody incubation with GBA Monoclonal Antibody, Unconjugated(bsm-52907R) at 1:200 overnight at 4°C, followed by conjugation to the bs-0295G-HRP and DAB (C-0010) staining.
Paraformaldehyde-fixed, paraffin embedded Human Lung Cancer; Antigen retrieval by boiling in sodium citrate buffer (pH6.0) for 15 min; Antibody incubation with GBA Monoclonal Antibody, Unconjugated(bsm-52907R) at 1:200 overnight at 4°C, followed by conjugation to the bs-0295G-HRP and DAB (C-0010) staining.
Paraformaldehyde-fixed, paraffin embedded Human Thyroid Cancer; Antigen retrieval by boiling in sodium citrate buffer (pH6.0) for 15 min; Antibody incubation with GBA Monoclonal Antibody, Unconjugated(bsm-52907R) at 1:200 overnight at 4°C, followed by conjugation to the bs-0295G-HRP and DAB (C-0010) staining.
25 ug total protein per lane of various lysates (see on figure) probed with GBA monoclonal antibody, unconjugated (bsm-52907R) at 1:2000 dilution and 4°C overnight incubation. Followed by conjugated secondary antibody incubation at r.t. for 60 min.

技术资料
技术资料






